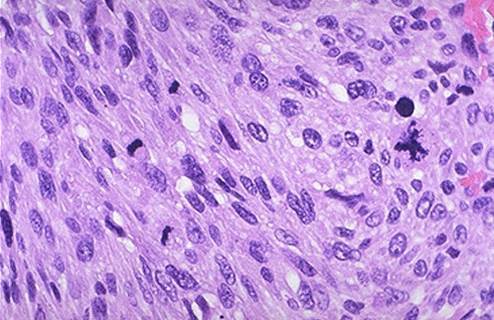

Tx imperforate hymen
foley catheter
ball of tissue on posterior wall of vagina
endometriosis
8y.o with stomach aches, bowel movements are thin and always scratching herself on examination there is white lesion around vulva with redness on borders dx?
lichen sclerosis
51 y.o with constant itching
had abnormal paps in past and at risk for HPV
what will you see on Bx?

hyperkeratosis and epidermal hyperplasia
Lichen simplex chronicus
26 y.o F at ED with staticus epilepticus
low BP
with rash, on arms and tampon was removed from vagina
culture was done on vagina
cocci gram + catalase +

staph aureus
Toxic shock syndrome
TSST-1 toxin
can have Ab to this if infected previously and appropriate immune response
19 y.o for papsmear
HPV liquid PCR + for type 16 and 18
image of cells shown
cervical Bx and endocervical cutterage negative, what should be done next?

large nuclei with scant cytoplasm
badness
high grade CIN III
need to do cone biopsy to sample cervix and get large portion of endocervical canal
19 y.o for papsmear
HPV liquid PCR + for type 16 and 18
image of cells shown
cervical Bx and endocervical cutterage negative, what should be done next?

small nuclei, lots of cytoplasm
ASCUS
atypical squamous cell of undetermined significance
inflammation induced? not sure
Need to re-screen
new born presents with fluid from eyes and aspirate is taken from swollen inflammed knee joint
glucose +
oxidase +
+ growth on thayer martin agar
diplococci
Dx?

gonorrhea
Following cells seen on sample from pap smear
what is it?

koilocytosis
HPV- both low grade and high grade can cause it
most likely low grade if this is only finding (type 6 or 11)
is maintained in nonintegrated episomal form
28 y.o F presenting with complaints of infertility
following histo from endometrial biopsy in workup
confident that?

proof that she has ovulated
early secretory phase
exudate characteristics of chlamydia
more clear
not as thick as gonorrhea
A 49 y o woman with a 30 year smoking history with irregular periods and abnormal bleeding.
bright red blood on her stools.
PE: moderately obese woman with large internal hemorrhoids identified on rectal examination.
Her GYN exam is normal. Endometrial biopsy is performed and the findings are seen in the image. The pathophysiology explaining her complaint is

no secretory changes
some mitotic figures
glands are not tubular like they should be because exposed to too much E
clusters of stromal cells (menstrual endometrium)
disordered proliferative pattern of shedding
A 31 y o female, G2;P4, presents to your office complaining of infertility. As part of your questioning you learn she is day 27 in her cycle and should menstruate in a day or two. An endometrial biopsy is performed and is seen in the image. The most likely explanation for her infertility is

endometrium does not match the date it should be
A 58 y o female presented with abnormal bleeding. Endometrial biopsy demonstrated complex hyperplasia with atypia. Endometrial curettage demonstrated complex hyperplasia with atypia. Hysterectomy was performed and the opened uterus is seen in the image. A section was taken from the area indicated and examined by the pathologist. The finding(s) (are)

Dx for invasion
A 54 y o female presents to your office complaining of irregular bleeding and a “fullness sensation” in her lower abdomen. Physical examination reveals a moderately obese woman. GYN exam reveals a probable 10 cm nodule associated with her uterus. Endometrial biopsy is performed and the patient is referred to radiology for a CT of the pelvis which is interpreted “Probable leiomyoma, Fundus of Uterus, (18 cm in diameter)”. The endometrial biopsy is read as “Insufficient for Diagnosis” so the patient undergoes an endometrial curettage which is seen below. What might you do next?
smooth muscle tumor
many many mitotic figures
hysterectomy
The x-ray seen in the image is from a 16 y o female who presented to her family physician for a yearly check up. Physical examination revealed lower abdominal fullness.
Finding suggests what?

mature teratoma(contains 2-3 germ lines)
can arise from ovum after first meiotic division
If papillary malignant cells with psammoma bodies were to be found on cytology following aspiration, the cells would most likely
high grade
have to look for invasian with pathology to determine invasive or not
produce MUC16 gene
frozen sections below of adenexal mass that has yellow fluid

not invading cyst
borderline papillary serous cystadenoma
not benign. borderline because of amount of papillaes ad atypia
cyst emptied that has thick mucous fluid
mcroscopy seen below
what mutation does mass most likely have

looks benign, smooth borders
benign mucinous cystic adenoma
mutation: PTEN and KRAS proto-oncogene mutation
23 y.o obese female has hair on face and acne
complaining of infertility
abdominal U/S as follows
expected lab findings?

elevated fasting insulin lvel
elevated testosterone, DHEAS, andostenedione levels
abnormal thyroid hormone levels (can be all over the place)
high prolactin level
LH:FSH>2:1
A 48 y o obese woman presents to your office complaining of MMR. Endometrial biopsy is obtained and the findings are seen in the image. The pathology report states, Complex hyperplasia with atypia”. You would suggest

fractional D&C
because high likelyhood of cancer.
make sure endocervical canal is not involved before hysterectomy
Sx would you expect from subserosal lesion
posterior uterus next to spine
back pain and vaginal bleeding
knots in umbilical cord are associated with?
abnormally long cords
very active fetus
umbilical cord shown
why did fetus die?

decreased O2 delivery to fetus